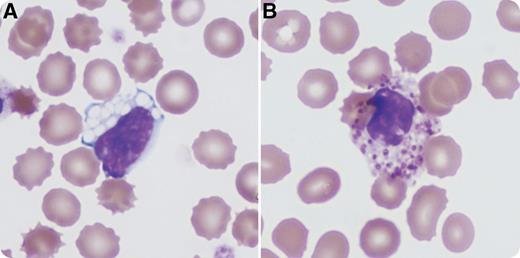
This peripheral blood is from a 3-month-old male patient with a prior diagnosis of GM1 gangliosidosis type I, who was admitted with fever and leukocytosis. There is a family history of 2 siblings with GM1 gangliosidosis. Cellulitis was diagnosed and successfully treated with antibiotics. This photomicrograph depicts the typical peripheral blood findings in GM1 gangliosidosis: a vacuolated lymphocyte (panel A) and an eosinophil with enlarged and sparse granules (panel B). Large, sharply defined vacuoles in mature lymphocytes may suggest any of several lysosomal storage diseases. The additional finding of the abnormal eosinophilic granulation is characteristic of GM1 gangliosidosis specifically. / GM1 gangliosidosis is an autosomal recessive lysosomal storage disorder caused by mutations in the GLB1 gene, which codes for β-galactosidase. The incidence is estimated to be between 1 in 100 000 to 200 000 live births. Type I is the most severe form and results in neurologic impairment caused by accumulation of GM1 gangliosides, typically within the first 6 months of life. Other features include a macular cherry-red spot, coarse facies, and hepatosplenomegaly. Vacuolated lymphocytes and eosinophils with abnormally sparse and enlarged granules are characteristic findings in the peripheral smear. Supportive care is typically given, because there is no effective treatment of the underlying disorder.

This peripheral blood is from a 3-month-old male patient with a prior diagnosis of GM1 gangliosidosis type I, who was admitted with fever and leukocytosis. There is a family history of 2 siblings with GM1 gangliosidosis. Cellulitis was diagnosed and successfully treated with antibiotics. This photomicrograph depicts the typical peripheral blood findings in GM1 gangliosidosis: a vacuolated lymphocyte (panel A) and an eosinophil with enlarged and sparse granules (panel B). Large, sharply defined vacuoles in mature lymphocytes may suggest any of several lysosomal storage diseases. The additional finding of the abnormal eosinophilic granulation is characteristic of GM1 gangliosidosis specifically.
GM1 gangliosidosis is an autosomal recessive lysosomal storage disorder caused by mutations in the GLB1 gene, which codes for β-galactosidase. The incidence is estimated to be between 1 in 100 000 to 200 000 live births. Type I is the most severe form and results in neurologic impairment caused by accumulation of GM1 gangliosides, typically within the first 6 months of life. Other features include a macular cherry-red spot, coarse facies, and hepatosplenomegaly. Vacuolated lymphocytes and eosinophils with abnormally sparse and enlarged granules are characteristic findings in the peripheral smear. Supportive care is typically given, because there is no effective treatment of the underlying disorder.
This peripheral blood is from a 3-month-old male patient with a prior diagnosis of GM1 gangliosidosis type I, who was admitted with fever and leukocytosis. There is a family history of 2 siblings with GM1 gangliosidosis. Cellulitis was diagnosed and successfully treated with antibiotics. This photomicrograph depicts the typical peripheral blood findings in GM1 gangliosidosis: a vacuolated lymphocyte (panel A) and an eosinophil with enlarged and sparse granules (panel B). Large, sharply defined vacuoles in mature lymphocytes may suggest any of several lysosomal storage diseases. The additional finding of the abnormal eosinophilic granulation is characteristic of GM1 gangliosidosis specifically.
GM1 gangliosidosis is an autosomal recessive lysosomal storage disorder caused by mutations in the GLB1 gene, which codes for β-galactosidase. The incidence is estimated to be between 1 in 100 000 to 200 000 live births. Type I is the most severe form and results in neurologic impairment caused by accumulation of GM1 gangliosides, typically within the first 6 months of life. Other features include a macular cherry-red spot, coarse facies, and hepatosplenomegaly. Vacuolated lymphocytes and eosinophils with abnormally sparse and enlarged granules are characteristic findings in the peripheral smear. Supportive care is typically given, because there is no effective treatment of the underlying disorder.
For additional images, visit the ASH IMAGE BANK, a reference and teaching tool that is continually updated with new atlas and case study images. For more information visit http://imagebank.hematology.org.
This feature is available to Subscribers Only
Sign In or Create an Account Close Modal